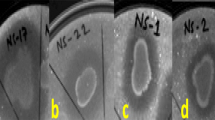
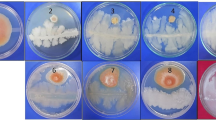

Abstract
In the present study, twenty-six rhizobacterial antagonists of Fusarium oxysporum f. sp. ciceris (Foc), isolated from Foc infected chickpea fields were evaluated for their protein secretion. Exoprotein liberation by rhizobacterial antagonists lied in the range between 28.2 and 795 μg/ml, where maximum exoprotein was recorded by isolate Ps47, followed by Ps45 (795.0 µg/ml) and Ps44 (578.2 μg/ml). Further observation of hydrolytic proteins, revealed most of the bacterial antagonists to exhibit proteolytic, amylolytic, chitinolytic as well as cellulose degrading potential on minimal agar plates, supplemented with respective substrates. About 73 and 80% of the antagonists were found positive for chitinolytic and cellulolytic activity respectively, where isolate Ba18 scored maximum hydrolytic index for chitin and Ba10 exhibited highest cellulose hydrolytic index of 2.1. Assay for proteases, denoted 84.6% of isolates to produce lysis zones, when gelatin was used as protein source, where 80% of isolates showed hydrolytic activity for casein supplemented minimal salt (MS) agar. SDS-PAGE analysis for the presence of hydrolytic enzymes in the extracellular crude protein revealed Pseudomonas isolate Ps45 and Bacillus Ba1a to exhibit a range of protein bands between 5 and 150 kDa, belonging to several group of proteases, amylases, chitinases and cellulases. Scanning Electron Microscopic examinations of the interaction zones between fungal pathogen (Foc) and isolate Ps45, revealed hyphal distortion due to lysis effect with scanty mycelial growth compared to control, that was maintained without any bacterial treatment. Screening and characterization of bacterial strains with the ability to produce a range of lytic enzymes will greatly enhance our understanding for their exploitation in the management of soil borne fungal pathogens.
Similar content being viewed by others
Avoid common mistakes on your manuscript.
Introduction
Management of plant diseases has major economic significance as well as a crucial role in food safety. Biological control using microbes is becoming a critically needed component of plant disease management, particularly in reducing the impact of root diseases (Fira et al. 2018; Jensen et al. 2016). Among the root infectious microorganisms, soil and seed-borne plant pathogenic fungal pathogens such as Fusarium oxysporum, F. solani, F. eumartii, Phytophthora infestans, Pythium ultimum, Sclerotium rolfsii, Macrophomina phaseolina, Rhizoctonia solani, R. bataticola, and Verticillium albo-atrum contribute to major loss of agricultural crops every year (Nion and Toyota 2015; Rajput et al. 2019; Kumari and Khanna 2020). Though a number of chemical fungicides are available for the management of these phytopathogens, but due to their inconsistency, non-availability for some pathogens, non-targeted results and development of resistance in fungal pathogens, there is a need for some safe, more specific and eco-friendlier alternative. At present biological control using bacterial and fungal antagonists, has become a very important technique to control soil borne fungal pathogens (Huang et al. 2020; Smolińska and Kowalska 2018). Strains of Trichoderma spp. and non-pathogenic isolates of F. oxysporum and some rhizobacteria especially Pseudomonas spp. and Bacillus spp. isolated from the rhizospheres of crop plants, are well reported to be effective to control several soil borne plant pathogens (Raza et al. 2017; Pushpavathi et al. 2016). These biological agents not only serve as biopesticides but also as plant growth promoters by enhancing the plant’s growth via facilitating the accession of several essential nutrients from the soil. Moreover, the use of biocontrol agents is much safer and is presumed to be eco-friendly (Kumari and Khanna 2018).
Biocontrol agents employ mechanisms like rapid solubilization and mineralization of essential nutrients, antibiosis, inhibition of plant ethylene synthesis and siderophore production for inducing nutrient deprived conditions for suppression of plant pathogens. In addition, one of the most important mechanism of the rhizobacterial biocontrol agents is hyperparasitic activity, in which they attack plant pathogens by excreting cell wall hydrolases (Joshi et al. 2012). Antagonistic microorganisms involved in hyperparasitism, invade the fungal pathogens by excretion of extracellular enzymes such as β-1, 3-glucanase, chitinase, cellulase, dehydrogenase, lipase, phosphatase and protease that can lyse pathogen cell walls or cause degradation of chlamydospores, conidia, sporangia, and zoospores resulted in direct inhibitory effect on growth as well as the resting structures of the pathogens (Hayat et al. 2010). Among these, chitinase and β-1, 3-glucanase are considered as the major lytic enzymes of practical significance (Avinash and Rai 2016). Chitinases are important, as they hydrolyse chitin [a linear ß-(1, 4)-linked N-acetyl glucosamine polysaccharide], contributing 22–44% of the fungal cell walls, thus disrupt the outer lining of the pathogens and release the cytoplasmic fluid out of the cell (Manjula and Podile 2005). In genus Bacillus, chitin degrading activity is very common as they produce chitobiosidase reported to degrade the hyphal cell walls of various root associated fungal pathogens (Gajera et al. 2016). β-1, 3-glucanase second important enzyme produced by antagonistic microorganisms, involved in the biological control of phytopathogenic fungi by the degradation of glucan content in the fungal cell walls. Excretion of hydrolytic enzymes such as chitinases and glucanases, lipases and proteases by B. subtilis (Schallmey et al. 2004), B. amyloliquefaciens (Solanki et al. 2012), B. cereus (Namasivayam et al. 2011), B. megaterium etc. (Sekhon et al. 2006) and P. fluorescens (Radjacommare et al 2010), P. cepacia, P. syringae, P. putrifaciens and P. fragi (Maharana and Ray 2013), have been well documented. Such protein secretion by plant beneficial rhizospheric bacteria plays an important role in hyperparasitism of several fungal pathogens, thereby reduce the phytopathogenic effect on host plants (Jadhav et al. 2017).
Hydrolytic enzymes like proteases and lipases, cause degradation of various proteins and lipids adhered to the cell walls or inside the cells of the pathogens. Extracellular enzymes also include wide range of solubilizing enzymes that enhance the nutrient availability of the plants as well the producing microorganism (Avinash and Rai 2016; Hayat et al. 2010). They confer antagonistic activity as they interfere indirectly with the cell wall integrity and metabolic activities inside the cells of fungal phytopathogens (Nadeem et al. 2013). Several reports for the exhibition of such type of hyper-parasitic activity by an array of rhizobacteria are there in which bacteria belonging to the genus mainly Bacillus, Pseudomonas and Rhizobium have been found to cease the growth of a range of soil borne fungal pathogens such as F. oxysporum, R. solani, P. ultimum, S. rolfsii etc. via the production of hydrolytic enzymes (Compant et al. 2005; Kumar and Johri 2011; Schallmey et al. 2004; Solanki et al. 2012). Employing bacterial communities exhibiting hydrolytic activity as biocontrol agents, may help in reducing the risk of fungal attack and can help in improving the crop productivity of infested soils (Gupta et al. 2015; Upadyay et al. 2012).
As production and liberation of extracellular enzymes by microorganisms is reported to be inducible in the presence of substrates, the heavily infected soils with fungal pathogens carry high levels of chitin, cellulose, proteins, lipids and organic matter, thereby stimulate hydrolytic activity of hyperparasitic microorganisms (Manjula and Podile 2005). Before evaluating their performance under field conditions, testing of hydrolytic attributes of biocontrol agents under laboratory conditions is a pre requisite. In the present study rhizobacterial antagonists, isolated from Foc infected chickpea fields, previously screened for their antagonistic activity against Fusarium oxysporum f. sp. ciceris (Kumari and Khanna 2018), causing 100% loss in chickpea due to fusarium wilt (Pande et al. 2010), were further investigated for diverse extracellular hydrolytic protein secretions. Revealing the efficacy of these potential antagonists for hydrolases secretion will not only provide an eco-friendly and sustainable alternative for chemical fungicides to manage Foc in chickpea, but also other soil borne fungal pathogens due to their similar mechanism of action on cell wall components of a range of phytopathogenic fungi.
Materials and methods
Bacterial isolates
Twenty-six rhizobacterial cultures (11 Bacillus sp. and 15 Pseudomonas sp.), previously screened for their antagonistic activity against F. oxysporum f. sp. ciceris (Foc) under in vitro conditions (Kumari and Khanna 2018), were selected for evaluation of their efficacy to secrete extracellular hydrolytic enzymes. Potential antagonists were also investigated for their hyperparasitic activity on Foc via the production of diffusible hydrolytic enzymes using Scanning Electron Microscopy (SEM).
Fungal pathogen
Chickpea wilt causing fungal pathogen Foc, previously examined for its pathogenic effect on chickpea, was procured from Department of Plant Breeding and Genetics, Punjab Agricultural University, Ludhiana and was maintained on Potato Dextrose agar slants (Kumari and Khanna 2014).
Estimation of rhizobacterial exoproteins
All the reagents were prepared following the method of Lowry et.al (1951). For reaction mixture, to 1 ml of cultural supernatant, 5 ml of freshly prepared alkaline Copper sulphate reagent was added and mixed thoroughly. After 10 min, 0.5 ml of Folin’s reagent was added and absorbance was read at 620 nm after 30 min of incubation at 28 ± 2 °C. Total protein was expressed as (μg/ml) using bovine serum albumin (BSA) for standard curve preparation.
Detection of lytic enzymes
Detection of chitinase
Minimum salts agar (MSA) supplemented with (1% w/v) colloidal chitin was spot inoculated with a loop full of 24 h grown culture of rhizobacterial antagonists. Test plates were incubated at 30 °C for 48 h and were examined for the zones of hydrolysis indicative of chitinase secretion.
Colloidal chitin suspension was prepared by following the method of Skujin et al. (1965). One-gram practical grade chitin powder was suspended in 100 ml cold (4 °C) hydrochloric acid (10 N) and allowed to stand at 4 °C. After 24 h, the viscous syrup solution was filtered through glass wool and the filtrate collected in 500 ml of cold (4 °C) distilled H2O, was being stirred vigorously during the operation by a magnetic stirrer to covert chitin in a dispersed colloidal state. The colloidal suspension (now on Whatman No.1 filter paper) was washed several times with distilled H2O to remove any trace of residual acid. The colloidal chitin was collected in 100 ml of 0.05 M Na3PO4 buffer (pH 6.0) to provide colloidal chitin suspension containing around 10 mg chitin per ml.
Detection of β- 1, 4 glucanase
Minimum salts agar (MSA) medium plates supplemented with carboxy methyl cellulose (CMC) (1% w/v) were spot inoculated with rhizobacterial isolates with the help of inoculating loop. Plates were incubated on biological oxygen demand (BOD) incubators at 30 °C for 48 h. Following the incubation, the agar plates were flooded with the Congo red solution for 15 min and were examined for zones of hydrolysis after washing the dye, indicating β-1, 4 glucanase activity.
Detection of protease
Minimum salts agar (MSA) plates containing 1% w/v casein and gelatin were spot inoculated with 24 h old bacterial cultures, followed by incubation at 30 ºC for 48 h. Observations were made for clear zones of hydrolysis indicating protease secretion.
Statistical analysis
Data was analysed by Analysis of variance (ANOVA) using SAS Software, version 9.3. The mean separation of observations was accomplished by using Tukey’s Honestly Significant Difference test and the critical difference (C.D.) values were calculated at the p ≥ 0.05 level to signify the differences between the bacterial isolates.
SDS PAGE analysis of extracellular proteins
Extraction of extracellular proteins by TCA-acetone protein precipitating method
Bacterial cultures, selected on the basis of their efficiency to liberate hydrolytic enzymes under in vitro conditions were grown in nutrient broth for 48–72 h followed by centrifugation at 5000 rpm for 10 min. To 5 ml of bacterial culture supernatant, 40 ml 100% ice cold acetone and 5 ml of 100% trichloroacetic acid (w/v) were added and allowed to precipitate for 1 h at − 20 °C. Then the precipitates were centrifuged at 11,500 rpm for 15 min at 4 °C and the supernatant was discarded. The precipitates were washed thrice with 1 ml ice cold acetone followed by centrifugation to remove all of the TCA. The pellets were air dried to remove the acetone as it makes the resuspension more difficult. The pellet was stored at 20 °C, and was dissolved in sodium phosphate buffer (7.0 pH) (when required), by repeated pipetting up and down to break up the pellet. Then the samples were allowed to sit at room temperature for 1 h, vortexing approximately for 10 min before use.
SDS-PAGE profiling of extracellular proteins
The molecular weight of the crude proteins was determined by Sodium dodecyl sulphate—Poly acrylamide gel electrophoresis (SDS-PAGE). Bacterial proteins were allowed to run through 5% stacking and 10% resolving gel at 15 mA fixed current, along with 5–245 kDa protein ladder. After the run, the gel was stained with Coomassie brilliant blue (R250) and destained for 8–10 h with destaining solution prepared by adding methanol, acetic acid and water in 30:10:10 ratio. Observations for the presence of protein bands corresponding to various lytic enzymes were made for the selected potential isolates (Sasirekha et al. 2012).
Molecular characterization of bacterial antagonist
The selected bacterial cultures were characterized by PCR amplification method using Bacillus and Pseudomonas specific primers. The selection of specific primers for these two genera i.e. Bacillus and Pseudomonas was done on the basis of the closeness of morphological and biochemical characteristics of the selected bacterial cultures to these two genera as described in our previous work (Kumari and Khanna 2018). Bacterial DNA extraction was performed as per the procedure described in Kumari et al. (2016).
PCR amplification
Polymerase chain reaction (PCR) amplification of genomic 16S rRNA was carried out using BA-GS-Forward (AGAGTTTGATCC TGGCTCAG) and BA-GS-Reverse (TACGGCTACCTT GTTACGACTT) specific primers for genus Bacillus. For Pseudomonas PA-GS-Forward (GACGGGTGAGTAATGCCTA) and PA-GS-Reverse (CACTGGTGTTCCTTCCTATA) genus specific primers were used as described by (Ardura et al. 2013). PCR reaction mixture (25 μl) comprised 2 units Taq DNA polymerase, 0.2 mM each of the four dNTPs and 30 ng of bacterial extracted template DNA, 25 pmol each of the forward and reverse primers, 1.5 mM Mg2+ and 10X buffer. The reaction was set at 35 cycles of amplification with the conditions included 1 min for denaturation at 94 °C, 1 min for primer annealing at 52 °C, 1 min for elongation at 72 °C followed by final extension for10 min at 72 °C.
Agarose gel electrophoresis
After the amplification, the PCR product (5 μl) was run on 1.2% (wt/vol) agarose gel immersed in Tris Borate Ethylene diamine tetra-acetic acid buffer (pH 8.3) at 40 V for 1.5 h. Then the agarose gel stained with ethidium bromide was visualized using UV transilluminator.
Scanning electron microscopic (SEM) examination of the effect of crude protein extract of potential antagonist on test fungus
The effect of crude protein extract on fungal pathogen was examined by dual culture well agar plate assay where, 5 mm agar disc of test fungus i.e. F. oxysporum f. sp. ciceris (Foc) was placed on PDA plates at the centre and 20 µl of crude extract of a selected potential antagonist was released in a well, prepared by removing agar bit aseptically from the agar surface with a sterile cork borer at least 3 cm apart from the fungal inoculum. The PDA plates with test fungal pathogen at the centre without bacterial antagonists served as control. A separate agar disc containing healthy mycelial growth of Foc, having no effect of bacterial crude was maintained as control to compare the visual changes in the treated and untreated hyphae under SEM. The inoculated plates were incubated at 28 ± 2 °C for 5 days till, clear zone of inhibition of the test fungus was observed. From the interaction sites between crude extract and test fungus, a disc of 10 mm in diameter containing peripheral hyphae of the pathogen was picked for SEM examination. The selected agar disc was treated with 2.5% Glutaraldehyde at 4 °C for 24 h, followed by immersing the disc thrice in 0.1 M Cacodylate buffer. Then the sample was dipped in 1% Osmium tetra-oxide, followed by dehydration using graded aqueous ethyl alcohol of increasing series concentrations i.e. 30, 50, 70, 90, 95 and finally 100% ethanol for five minutes. Then the sample was completely dried using critical point dryer and was subjected to anion sputtering unit for coating the bit with Gold–Palladium (Kumari et al. 2016). After that the gold–palladium coated sample was examined under scanning electron microscope, SEM unit at Electron Microscopy and Nanoscience (EMN) laboratory, Punjab Agricultural University, Ludhiana.
Results and discussion
Assay for extracellular proteins
Extracellular protein secretions by PGPR majorly contribute cell wall degrading enzymes that play a very crucial role in the antibiosis against various phytopathogens (Maksimov et al. 2013; Neeraja et al. 2010; Dunne et al. 2000). All the rhizobacterial isolates were found positive for exoproteins secretion in liquid medium ranging from 28.2 to 795.0 μg/ml. Isolate Ps47 exhibited highest protein liberation of 795.0 μg/ml, followed by Ps45 (642. 7 μg/ml) and Ps44 (578.2 μg/ml) (Table 1). Protein liberation efficacy was significantly variable among the bacterial isolates as previously observed for their antagonistic activity against Foc (Kumari and Khanna 2018). In a similar study conducted by Basha and Ulaganathan (2002), extra-cellular protein precipitates from a strain of B. subtilis culture filtrate showed growth-retarding and mycolytic effect on the test fungus Curvularia lunata. Ajit et al. (2006), reported the antagonistic role of bacterial exoproteins from fluorescent Pseudomonas strains against F. oxysporum f. sp. dianthi.
Liberation of hydrolytic proteins is one of the mechanisms implicated by antagonistic rhizobacteria for halting the growth of fungal pathogens present in close vicinity (Silva et al. 2018; Sabaratnam and Traquair 2015). In addition to their direct role in antagonistic activity, bacterial exoproteins help in neutralizing and thus reducing the effect of certain toxic metabolites produced by the pathogens in the plant biosphere via indirect mechanism (Kim et al. 2013). Moreover, some of the bacterial protein secretions also help in solubilization or mineralization of essential nutrients in the soil and help in maintaining the soil texture, suitable for the plant growth (Avinash and Rai 2016).
Fluorescent Pseudomonas and Bacillus species are well known biocontrol agents for the suppression of plant pathogenic microorganisms by the secretion of extracellular metabolites such as phenazine and its derivatives, exerting inhibitory effect even at very low concentrations (Bach et al 2016; Namasivayam et al. 2011). In a study conducted by Manjula and Podile (2005), enhanced production and liberation of extracellular proteins such as β-1,4-N-Acetyl glucosaminidase and β-1,3-glucanase by B. subtilis was recorded when chitin was added as substrate to the culture medium, indicating the inducible nature of mechanisms involved in protein synthesis and secretion.
Assay for lytic enzymes
Several bacterial communities such as B. subtilis, B. mycoides, Burkholderia cepacia and Paenibacillus riograndensis, P. fluorescens, P. cepacian, P. gessardii and Enterobacter agglomerans in the plant rhizosphere release chitinases, cellulases, hemicellulases and proteases that are able to hydrolyse chitin, cellulose, hemicelluloses and proteins respectively, contribute in the direct suppression of several plant pathogens (Bach et al. 2016; Chang et al. 2010; Kumudini et al. 2017; Saraf et al. 2014). Among the 26 Foc, rhizobacterial antagonists, 19 isolates exhibited chitinolytic activity (Fig. 1a), maximum activity was recorded by Ba18 with the hydrolytic index of 4.8 ± 1.11. Chitinases play a vital role in the antagonistic activity of PGPRs against fungal pathogens as chitin contributes the major content of their cell walls (Brzezinska et al. 2014). In a study conducted by Ramesh et al. (2009), about 75.0 and 66.7% inhibition of sclerotia of R. solani by the crude chitinase after 8 days of incubation period from two Pseudomonas isolates i.e. EB69 and EC18, was recorded. In the same study, the inhibiting effect of crude enzyme was observed on sclerotia bodies of S. rolfsi. Ajit et al. (2006), reported the chitinolytic activity of fluorescent Pseudomonas against F. oxysporum f. sp. dianthi causing carnation wilt. All these studies including the present one, indicate the potential of some bacterial strains to produce active chitinases in medium that could be effective in inhibiting the growth as well as germination of resting spores of many phytopathogenic fungi.
Zones of lysis on respective agar media by rhizobacterial isolates. a Chitinase activity on Chitin supplemented minimal medium, b β-1, 4-glucanase activity on carboxy methyl cellulose supplemented minimal salts (MS) agar medium, c α -amylase activity on starch supplemented MS agar medium, d Protease (Caseinase) activity on casein supplemented MS agar medium, e, f Protease (Gelatinase) activity on gelatin supplemented MS agar medium
Another group of enzymes include cellulases consisting of exo- and endo- β-1,4-glucanases that cleave the complex cellulose structure into the simpler ones along with β-1,4-glucosidase that degrade celluloses into glucose subunit (Chaiharn et al. 2008). About 80% of the Foc antagonists were found to exhibit β-1–4 glucanase activity to hydrolyse carboxy methyl cellulose (CMC) (Fig. 1b), maximally with Ba10 holding the hydrolytic index of 2.1 ± 0.38 (Table 2). Starch hydrolysis was recorded by all the antagonists, indicating the release of amylase (Fig. 1c). Proteolytic enzymes also play a very important role in biological control of phytopathogens. Among the antagonists, 84.6% of the isolates were found to be proteolytic when gelatin was used as a protein substrate (Fig. 1e, 1f). For casein, 80% of the antagonists recorded positive for the hydrolysis, that was slightly less compared to that observed in case of gelatin, might be due to difference in capability of bacterial cultures to hydrolyse proteins of different origin and composition (Fig. 1d). For caseinase activity, Ba1a and Ps45 isolates were found to be most efficient with proteolytic index of 2.5 ± 0.15 and 2.5 ± 0.14 respectively, whereas for the animal-based protein (gelatin) hydrolytic activity marked Ba19, Ba4 and Ps47 as maximum proteolytic index holders.
Observations revealed the isolates Ba1a, Ba19, Ps45 and Ps47 to be potent lytic enzymes producers (Table 2). In a study conducted by Kamensky et al. (2003), observations revealed that despite the chitinases, several proteases released by antagonistic bacteria have an important role in suppression of germination as well as growth of several soil born phytopathogenic fungi. Kumar et al. (2012) reported several bacterial sp. of Bacillus producing cell wall degrading enzymes viz., chitinase, β-1, 4-glucanase and protease to degrade the fungal cell wall components attacking chitin, glycosidic and peptide bonds. Some of the isolates (examined in the current study) exhibiting the antagonistic activity to Foc, reported in one of our previous studies (Kumari and Khanna 2018), did not exhibit one or more lytic enzymes activity suggesting that production of hydrolytic enzymes can be one the antagonistic but not always the sole mechanism for inhibition of fungal growth. Furthermore, it has been reported that some of the bacterial strains show appreciable chitinase activity, but do not inhibit the growth of fungal pathogens, suggesting that production of hydrolytic enzymes is not always correlated with the antiphytopathogenic effect (Sindhu and Dadarwal 2001).
Detection of lytic enzymes by SDS-PAGE
To determine the ability of rhizobacterial isolates to secrete antifungal proteins, eight potential Foc antagonists i.e. Ba1a, Ba18, Ba19, Ps10b, Ps14, Ps45, Ps47 and Ps44, selected on the basis of exoproteins and lytic enzymes production, were analysed for the presence of various hydrolytic enzymes. For that purpose, extracellular proteins extracted and purified by TCA-acetone precipitation of cell-free culture supernatants, were profiled by SDS polyacrylamide gel electrophoresis. Coomassie brilliant blue staining revealed a wide range of protein bands with an apparent molecular mass between 5- 150 kDa, whereas protein composition was recorded with high variability among the isolates (Fig. 2). The antagonists, Ba1a and Ps45 were recorded with highly dense protein profile, comprising more than 15 distinct bands over the stained polyacrylamide gel (Fig. 2). The protein profiles of almost all the isolates showed bands between 25 and 30 kDa, presenting proteases, especially P1 and P2 with molecular weight of 28 and 25 kDa respectively, as indicated by Annamalai et al. (2014), when evaluated proteases of Bacillus megaterium by SDS-PAGE method. Shahbazi et al. (2012) reported most of bacterial strains to comprise the molecular mass of purified proteases in the range of 30–50 kDa, and in the present study most of the isolates were observed with polypeptide chains in the same range, inferring the liberation of a variety of proteases in the growth medium. Among all the lytic enzymes, proteases constitute one of the most important groups of hydrolytic enzymes and they account for approximately a quarter of the total global microbial enzyme production (Mala and Srividya 2010). Observation for the stained gel recorded, six isolates i.e. Ba1a, Ba18, Ba19, Ps44, Ps45 and Ps47, with apparently pure protein bands of 45 kDa, supported the observations made by Ueda et al. (2005), where a thermophilic bacterium belonging to Ralstonia sp. showed a distinct band of 45,000 Da, that was reported to belong ChiB group of chitinases. Sutrisno et al. (2004) also reported Chitinase B (ChiB) enzyme in chitin degrading bacteria with a protein band of same size as observed in the present study i.e. 45 kDa. Other classes of chitinases i.e. Chi50 and Chi60 with band size of 50 and 60 kDa (Ruiz-Sanchez et al. 2005) were also observed in the case of Ba1a, Ba19, Ps44, Ps45 an Ps47 bacterial antagonists. However, Chi 180 with polypeptide bands of apparently 180 kDa was obtained in only 2 isolates i.e. Ba19 and Ps45, classified as N-acetyl glucosaminidase in the similar study conducted by Ruiz-Sanchez et al. (2005) (Fig. 2). In a similar study, Chao-Lin et al. (2009) reported two bands of 43 and 55 kDa in Aeromonas schubertii that were assumed to have maximum homology with Chi53 and Chi61, belonging to endochitinase family. Chitinase producing PGPR have been successfully used as anti-fungal, pest control and degradation agents at various suppressive soils sites (Gomez-Ramirez et al. 2004). Observations for protein bands belonging to cellulases, revealed four potential bands of 58, 72, 94 and 110 kDa according to the study conducted by Kohring et al. (1990), when SDS PAGE analysis for cellulases and xylanases was performed for subunit analysis of Clostridium thermocellum JW20. In corroboration to this study, Isolate Ps45, Ps47 and Ba1a were found to exhibit protein bands equivalent to 58, 72 and 94 kDa, however the protein band of 110 kDa was exhibited by only Ps45 along with two bacilli i.e., Ba1a and Ba18 (Fig. 2). Clear protein bands were expressed corresponding to 60 kDa in case of Ps45 and Ba1a, however diminished bands of the same molecular weight were also observed for Ba19, Ps44, Ps45 and Ps10b, contributing their amylolytic activity according to Xian et al. (2015), when Calcium independent α- amylase from Talaromyces pinophilus 1–95 was characterised using SDS-PAGE. However, in a study carried out by Sarian et al. (2012), an apparent mass of 95 Kda was observed from the purified enzyme from potato starch hydrolysing Microbacterium aurum strain B8.A that was visualized only in case of isolate Ps45 in the present study revealing its potential hydrolytic activity for carbohydrate-based molecules. Analysis for hydrolytic proteins provides a benchmark for the hyperparasic activity of antagonistic microorganisms and revealing antagonistic mechanisms at molecular level opens the door for screening potential antagonists with special metabolic tools to control several plant pathogens and hence the economic losses in the agricultural system.
Molecular identification of the potential antagonists
The PCR amplification studies using 16S-rDNA targeted genus-specific primers for Bacillus revealed all the three bacterial isolates (Ba1a, Ba18 and Ba19) to belong Bacillus sp. that were isolated from nutrient agar medium and were already tested for their characteristic dark blue/green colouration on Bacillus agar medium specific for Bacillus genus (Fig. 3a). The PCR amplification product for the bacterial isolates was recorded with molecular weight of approximately 1.5 bp, confirming their belongingness to Bacillus sp. (Fig. 4a) (Akbalık 2003; Kumari et al. 2016). The rest five pigment producing isolates (Ps10b, Ps14, Ps45, Ps47 and Ps44), previously isolated from King’s B medium (Kumari and Khanna 2018), phenotypically identified on Pseudomonas agar medium for the production of blue green or fluorescent green pigment (Fig. 3b), yielded a PCR product of 618 bp (Fig. 4b), confirming their identity as isolates belonging to Pseudomonas sp. supported by a study conducted by Spilker et al. (2004), where out of 42, 28 isolates were recorded positive for their molecular identification to belong Pseudomonas sp. using PA-GS forward and reverse primers with a product yield of same molecular weight. Several reports have confirmed Bacillus and Pseudomonas sp. as promising agents for disease management of several phytopathogens, due to their antagonistic behaviour (Ahemad and Kibret 2014; Gopalakrishnan et al. 2016; Leon et al. 2009). Bacilli have been well reported to liberate certain volatile, non-volatile and thermostable metabolites inferring antagonistic behaviour to many plant pathogens (Singh et al. 2014). Fluorescent Pseudomonas have also been well reported to produce a range of antibiotics like pyoluteorin (Plt), pyrrolnitrin (Prn), aerugine, oomycin A, kanosamine, 2,4 diacetyl phloroglucinol (DAPG), phenazine-1-carboxylic acid (PCA), phenazine-1-carboxamide (PCN), zwittermycin-A, pseudomonic acid, cepafungins, hydrocyanic acid and ammonia (Fernando et al. 2006; Rezzonico et al. 2007; Shalini and Srivastava 2007). Both of these genera have been well recommended as biocontrol agents due to their versatile inhibitory activity against soil borne phytopathogens (Trotel-Aziz et al. 2008; Wang et al. 2016).
PCR analysis of amplified products using genus specific primers, a Amplified product of 1.5 Kb using Bacillus genus specific primers (M: 1 Kb DNA ladder, Lane 1. Ba1a, Lane 2. Ba89, Lane 3. Ba19), b Amplified product 618 bp Kb using Pseudomonas genus specific primers (M: 1 Kb DNA ladder, Lane 1. Ps44, Lane 2. Ps45, Lane 3. Ps47, Lane 4. Ps10b, Lane 5. Ps14)
Effect of bacterial crude extract on test fungus
On the basis of protein secretion, hydrolytic enzyme production under in vitro conditions as well as SDS PAGE analysis, a Pseudomonas isolate Ps45 was selected to evaluate the visual effect of antagonistic bacterial secretions on the hyphal growth of Foc under SEM. The 50-scale bar magnified images of the zone of interaction between the bacterial crude protein extract and fungal growth, revealed the sectors of sparse hyphae, apparent contraction of hyphal dia with rough cell surface morphology (Fig. 5b, d), compared to thicker, uniform, dense hyphae observed in control (Fig. 5a, c). Moreover, the fungal growth was also restricted in terms of hyphal distortion and compaction as scanty hyphal growth was observed than the control. SEM investigations of 20 scale bar magnification further, disclosed the inhibitory effect, where flattening effect along with marks of lesions revealed the spurting of cytoplasmic fluid out of the hyphal cells, conferring non-uniform, deflated abandoned hyphae (Fig. 5d) as compared to uniform healthy ones in the control (Fig. 5c). This disorganization of the cytoplasm, could be due to lytic effect on the fungal cell walls by various enzymes and antibiotics liberated in the vicinity by rhizobacterial antagonists, one of the most important mechanisms to inhibit the pathogens (Abdel-Monaim et al. 2016). Distortion of fungal mycelium and induction of hyphal surface flaking has also been reported by Sadfi et al. (2002) due to lysis and bursting of cytoplasmic material. Such irregular, lysed hyphae with diminished fungal growth illustrate the antagonistic behaviour of pseudomonads probably due to the production of various allelochemicals (Granjo et al. 2007). Though the fungal pathogens utilize chitin apposition in their cell walls to reduce the inhibitory effect of antimetabolites, nonetheless antagonistic pseudomonads have also been reported to overcome such barriers to cause severe fungal cell injuries (Aziz et al. 2012; Kai et al. 2007). Similarly, Kumari et al. (2016), observed marked antagonistic effect on the hyphal structure when visualized the effect of Bacillus cultures secretions on Fusarium oxysporum f.sp. ciceris. All these observations exemplify the antagonistic behaviour of rhizobacterial isolates against fungal pathogens via the production and liberation of various lytic enzymes, antibiotics and other volatile and diffusible antimetabolites (Kumari and Khanna 2019).
Scanning electron microscope (SEM) of interaction between crude extract of bacterial antagonist and F. oxysporum. a, b scale bar-50 μm, c, d scale bar-20 μm. a, c Smooth, uniform, dense hyphae from Fusarium oxysporum f. sp. ciceris pure culture (Control). b, d Flattened, shrunken, sparse hyphal growth with lesions at linings due to the hydrolytic effect of crude extract
Conclusion
Species specific PCR amplification of rhizobacterial antagonists of Foc, confirmed the selected isolates, Ba1a as Bacillus spp. and Ps45 and Ps47 as Pseudomonas isolates. These bacterial antagonists produce a range of enzymes including proteases, chitinases, cellulases and amylases, exhibiting efficient hydrolytic activity to target cell walls of fungal phytopathogens. Biological evaluation of crude protein extract of a selected potential Pseudomonas isolate Ps45 using SEM, confirmed lysis along the hyphal cell wall lining in contrast to healthy regular, smooth surfaced hyphae in the fungal pathogen culture maintained as control, inferring the role of various hydrolytic proteins in disrupting the fungal pathogen’s growth. Characterization of antagonistic rhizobacterial communities exhibiting hydrolytic activity via liberation of a range of extracellular enzymes, will greatly enhance our understanding of their role in the management of several soil borne fungal phytopathogens on the condition of their similar effect under controlled glass house conditions as well as field conditions.
References
Abdel-Monaim MF, Mahmoud E, Ibrahim M, Fatma AM, Zeinab NH, Soliman S, Sobeiha A, Fatma M, Waked DA, Eleawa M, Salama A (2016) Efficacy of secondary metabolites and extracellular lytic enzymes of plant growth promoting rhizobacteria (PGPR) in controlling fusarium wilt of chickpea. Egypt J Agric Res 94(3):573–589
Ahemad M, Kibret M (2014) Mechanisms and application s of plant growth promoting rhizobacteri a: current perspective. J King Saud Univ Sci 26:1–20
Ajit NS, Verma R, Shanmugam V (2006) Extracellular chitinases of fluorescent pseudomonads antifungal to Fusarium oxysporum f. sp. dianthi causing carnation wilt. Curr Microbiol 52(4):310–316
Akbalık G (2003) Screening for industrially important extracellular enzymes from alkalophilic Bacillus genus, Master’s thesis, İzmir Institute of Technology.
Annamalai N, Rajeswari MV, Balasubramanian T (2014) Extraction, purification and application of thermostable and halostable alkaline protease from Bacillus alveayuensis CAS 5 using marine waste. Food Bioprod Process 92:335–342
Ardura A, Ana LR, Vazquez EG (2013) Genetic detection of Pseudomonas spp. in commercial amazonian fish. Int J Environ Res Public Health 10:3954–3966
Avinash TS, Rai VR (2016) Plant growth promoting rhizobacteria: a boon to agriculture. Int J Agric Food Sci 6(2):28–36
Aziz LM, Hamza SJ, Rahman AA (2012) Isolation and characterization of phenazine produced from mutant Pseudomonas aeruginosa. Al Anbar J Vet Sci 5(1):42–52
Bach ED, Santos SGD, de Carvalho FG, Lisboa BB, Passaglia LMP (2016) Evaluation of biological control and rhizosphere competence of plant growth promoting bacteria. Appl Soil Ecol 99:141–149
Basha S, Ulaganathan K (2002) Antagonism of Bacillus species (strain BC121) towards Curvularia lunata. Curr Sci 25:1457–1463
Brzezinska MS, Jankiewicz U, Burkowska A, Walczak M (2014) Chitinolytic microorganisms and their possible application in environmental protection. Curr Microbiol 68(1):71–81
Chaiharn M, Chunhaleuchanon S, Kozo A, Lumyong S (2008) Screening of rhizobacteria for their plant growth promoting activities. Curr Appl Sci Technol 8(1):18–23
Chang WT, Wag CM (2010) An antifungal chitinase produced by Bacillus subtilis using chitin waste as a crabon source. World J Microbiol Biotechnol 26:945–950
Chao-Lin L, Chia-Rui S, Fong-Fu H, Jeen-Kuan C, Pei-Tzu W, Shang- Hsin G, Wen-Chien L, Feng-Wei Y, Zachary BM, John T, Grosx ML (2009) Isolation and identification of two novel SDS-resistant secreted chitinases from Aeromonas schubertii. Biotechnol Prog 25(1):124–131
Compant S, Duffy B, Nowak J, Clement C, Barka EA (2005) Use of plant growth-promoting bacteria for biocontrol of plant diseases: principles, mechanisms of action, and future prospects. Appl Environ Microbiol 71:4951–4959
Dunne C, Moe-Loccoz Y, Bruijn FJ, O’Gara F (2000) Overproduction of an inducible extracellular serine protease improves biological control of Pythium ultimum by Stenotrophomonas maltophilia strain W81. Microbiology 146:2069–2078
Fernando WGD, Nakkeeran S, Zhang Y (2006) Biosynthesis of antibiotics by PGPR and its relation in biocontrol of plant diseases. In: Siddiqui ZA (ed) PGPR: biocontrol and biofertilization. Springer, Netherlands, pp 67–109
Fira D, Dimkić I, Berić T, Lozo J, Stanković S (2018) Biological control of plant pathogens by Bacillus species. J Biotechnol 285:44–55
Gajera HP, Savaliya DD, Hirapara DG, Patel SV, Golakiya BA (2016) Biocontrol mechanism of bacillus for fusarium wilt management in cumin (Cuminum cyminum L.). Current trends in plant disease diagnostics and management practices. Springer, Cham, pp 29–47
Gomez-Ramırez M, Rojas-Avelizapa LI, Rojas-Avelizapa NG, Cruz-Camarillo RC (2004) Colloidal chitin stained with Remazol Brilliant Blue R, a useful substrate to select chitinolytic microorganisms and to evaluate chitinases. J Microbiol Methods 56:213–219
Gopalakrishnan S, Vadlamudi S, Samineni S, Kumar CVS (2016) Plant growth-promotion and biofortification of chickpea and pigeonpea through inoculation of biocontrol potential bacteria, isolated from organic soils. Springer plus 5:1882–1893
Granjo CA, Dos RTA, Gambale W, Corrêa B (2007) Morphogenesis and growth kinetics of Fusarium verticillioides. Mycopathologia 164(3):119–126
Gupta G, Parihar SS, Ahirwar NK, Snehi SK, Singh V (2015) Plant growth promoting rhizobacteria (PGPR): current and future prospects for development of sustainable agriculture. J Microb Biochem Technol 7(2):96–102
Hayat R, Ali S, Amara U, Khalid R, Ahmed I (2010) Soil beneficial bacteria and their role in plant growth promotion. A review. Ann Microbiol 60(4):5795–5798
Huang LQ, Niu YC, Su L, Deng H, Lyu H (2020) The potential of endophytic fungi isolated from cucurbit plants for biocontrol of soilborne fungal diseases of cucumber. Microbiol Res 231:126369
Jadhav HP, Shaikh SS, Sayyed RZ (2017) Role of hydrolytic enzymes of rhizoflora in biocontrol of fungal phytopathogens: an overview. Rhizotrophs: plant growth promotion to bioremediation. Springer, Singapore, pp 183–203
Jensen DF, Karlsson M, Sarrocco S, Vannacci G (2016) Biological control using microorganisms as an alternative to disease resistance. Plant Pathogen Resistance Biotechnol 341–363
Joshi M, Shrivastava R, Sharma AK, Prakash A (2012) Screening of resistant verities and antagonistic Fusarium oxysporum for biocontrol of Fusarium Wilt of Chilli. Plant Pathol Microbiol 3(134):2
Kai M, Effmert U, Berg G, Piechulla B (2007) Volatiles of bacterial antagonists inhibit mycelial growth of the plant pathogen Rhizoctonia solani. Arch Microbiol 187:351–360
Kamensky M, Ovadis M, Chet I, Chernin L (2003) Soil-borne strain IC14 of Serratia plymuthica with multiple mechanisms of antifungal activity provides biocontrol of Botrytis cinerea and Sclerotinia sclerotiorum diseases. Soil Biol Biochem 35:323–331
Kim YC, Glick B, Bashan Y, Ryu CM (2013) Enhancement of plant drought tolerance by microbes. In: Aroca R (ed) Plant responses to drought stress. Springer, Berlin, pp 45–51
Kohring S, Wiegel J, Mayer F (1990) Subunit composition and glycosidic activities of the cellulase complex from Clostridium thermocellum JW20. Appl Environ Microbiol 56(12):3798–3804
Kumar PA, Johri BN (2011) Bacillus as PGPR in crop ecosystem. In: Maheshwari DK (ed) Bacteria in agrobiology: crop ecosystems. Springer, Berlin, pp 37–59
Kumar P, Dubey RC, Maheshwari DK (2012) Bacillus strains isolated from rhizosphere showed plant growth promoting and antagonistic activity against phytopathogens. Microbiol Res 167(8):493–499
Kumari S, Khanna V (2014) Effect of antagonistic rhizobacteria coinoculated with Mesorhizobium ciceris on control of fusarium wilt in chickpea (Cicer arietinum L.). Afric J Micro Res 8(12):1255–1265
Kumari S, Khanna V (2018) Biological management of vascular wilt of chickpea (Cicer arietinum L.) incited by Fusarium oxysporum f. sp. ciceris by antagonistic rhizobacteria co-inoculated with native mesorhizobium. Int J Curr Microbiol App Sci 7(1):920–941
Kumari S, Khanna V (2019) Biocidal mechanisms in biological control of fusarium wilt in chickpea (Cicer arietinum L.) by antagonistic rhizobacteria: a current perspective in soil borne fungal pest management. Int J Curr Microbiol App Sci 8(10):1494–1510
Kumari S, Khanna V (2020) Induction of systemic resistance in chickpea (Cicer arietinum L.) against Fusarium oxysporum f. sp. ciceris by antagonistic rhizobacteria in assistance with native mesorhizobium. Curr Microbiol 77(1):85–98
Kumari P, Khanna V, Sharma P, Kumari S (2016) Allelopathic effects of native Bacillus sp. against Fusarium oxysporum causing chickpea wilt. Allelopath J 38:77–90
Kumudini BS, Jayamohan NS, Patil SV (2017) Integrated mechanisms of plant disease containment by rhizospheric bacteria: Unraveling the signal cross talk between plant and fluorescent Pseudomonas. In: Agriculturally important microbes for sustainable agriculture. Springer, Singapore, pp. 263–291
Leon M, Yaryura PM, Montecchia MS, Hernandez AI, Correa OS, Pucheu NL, Kerber NL, Garcia AF (2009) Antifungal activity of selected indigenous Pseudomonas and Bacillus from the soybean rhizosphere. Int J Microbiol 5:1–9
Lowry OH, Rosbrough NJ, Farr AL, Randall RJ (1951) Protein measurement with Folin Phenol reagent. J Biol Chem 193:265–370
Maharana AK, Ray P (2013) Isolation and screening of cold active extracellular enzymes producing psychrotrophic bacteria from soil of Jammu City. Biosci Biotechnol Res Asia 10(1):267–273
Maksimov I, Abizgildina RR, Pusenkova LI (2011) Plant growth promoting rhizobacteria as alternative to chemical crop protectors from pathogens. Appl Biochem Microbiol 47:333–345
Mala M, Srividya S (2010) Partial purification and properties of a laundry detergent compatible alkaline protease from a newly isolated Bacillus species Y. Indian J Microbiol 50:309–317
Manjula K, Poldile AR (2005) Production of fungal cell wall degrading enzymes by biocontrol strain of Bacillus subtilis A F 1. Indian J Exp Biol 43:892–896
Nadeem SM, Naveed M, Zahir ZA, Asghar HN (2013) Plant–microbe interactions. Plant microbe symbiosis: fundamentals and advances. Springer, India, pp 51–103
Namasivayam E, Ravindar JD, Mariappan K, Akhil J, Mukesh K, Jayara R (2011) Production of extracellular pectinase by Bacillus cereus isolated from market solid waste. J Bioanal Biomed 3(3):70–75
Neeraja C, Anil K, Purushotham P, Suma K, Sarma P, Moerschbacher BM, Podile AR (2010) Biotechnological approaches to develop bacterial chitinases as a bioshield against fungal diseases of plants. Crit Rev Biotechnol 30:231–241
Nion YA, Toyota K (2015) Recent trends in control methods for bacterial wilt diseases caused by Ralstonia solanacearum. Microbes Environ. p ME14144
Pande S, Desai S, Sharma M (2010) Impacts of climate change on rainfed crop diseases: Current Status and Future Research Needs. Nat Symp Clim Change Rainfed Agric Hyderabad 18(20):55–59
Pushpavathi Y, Dash SN, Madhavi N, Deepika D (2016) Biological control of Fusarium wilt disease in banana with emphasis on Trichoderma spp. and Pseudomonas spp. Plant Arch 16(1):51–59
Radjacommare R, Venkatesan S, Samiyappan R (2010) Biological control of phytopathogenic fungi of vanilla through lytic action of Trichoderma species and Pseudomonas fluorescens. Arch Phytopathol Pflanzenschutz 43(1):1–17
Rajput RS, Singh P, Singh J, Ray S, Vaishnav A, Singh HB (2019) Seed biopriming through beneficial rhizobacteria for mitigating soil-borne and seed-borne diseases. In: Plant growth promoting rhizobacteria for sustainable stress management. Springer, Singapore. pp. 201–215
Ramesh R, Mathew T, Singh N (2009) Role of chitinolytic enzymes and volatile compounds produced by endophytic bacteria in the inhibition of mango (Mangifera indica L.) root rot pathogens. J Biol Control 23(4):433–441
Raza W, Ling N, Zhang R, Huang Q, Xu Y, Shen Q (2017) Success evaluation of the biological control of Fusarium wilts of cucumber, banana, and tomato since 2000 and future research strategies. Crit Rev Biotechnol 37(2):202–212
Rezzonico F, Zala M, Keel C, Duffy B, Moénne-Loccoz Y, Défago G (2007) Is the ability of biocontrol fluorescent pseudomonads to produce the antifungal metabolite 2, 4-diacetylphloroglucinol really synonymous with higher plant protection. New Phytol 173:861–872
Ruiz-Sanchez A, Cruz-Camarillo R, Salcedo-Hernandez R, Barboza-Corona JE (2005) Chitinases from Serratia marcescens Nima. Biotechnol Lett 27:649–653
Sabaratnam S, Traquair JA (2015) Mechanism of antagonism by Streptomyces griseocarneus (strain Di944) against fungal pathogens of greenhouse-grown tomato transplants. Can J Plant Pathol 37(2):197–211
Sadfi N, Cherif M, Hajlaoui MR, Boudabbous A, Belanger R (2002) Isolation and partial purification of antifungal metabolites produced by Bacillus cereus. Ann Microbiol 52(3):323–338
Saraf M, Pandya U, Thakkar A (2014) Role of allelochemicals in plant growth promoting rhizobacteria for biocontrol of phytopathogens. Microbiol Res 169(1):18–29
Sarian FD, van der Kaaij RM, Kralj S, Wijbenga DJ, Binnema DJ, Vander MMJ, Dijkhuizen L (2012) Enzymatic degradation of granular potato starch by Microbacterium aurum strain B8A. Appl Microbiol Biotechnol 93(2):645–654
Sasirekha B, Bedashree T, Champa KL (2012) Optimization and partial purification of extracellular phytase from Pseudomonas aeruginosa p6. Eur J Exp Biol 2(1):95–104
Schallmey M, Singh A, Ward OP (2004) Development in the use of Bacillus sp. for industrial production. Cna J Microbiol 50:1–9
Sekhon A, Dahiya N, Tewari RP, Hoondal GS (2006) Production of extracellular lipase by Bacillus megaterium AKG-1 in submerged fermentation. Indian J Biotechnol 5:179–183
Shahbazi M, Reza H, Heidari K (2012) A novel low molecular weight extracellular protease from a moderately halophilic bacterium Salinivibrio sp. strain MS-7: production and biochemical properties. Mol Biol Res Comm 1(2):45–56
Shalini SR (2007) Screening for antifungal activity of pseudomonas fluorescens against phytopathogenic fungi. Internet J Microbiol 5(2):1–6
Silva AKS, Silva TRN, Nicoli JR, Vasquez-Pinto LMC, Martins FS (2018) In vitro evaluation of antagonism, modulation of cytokines and extracellular matrix proteins by Bifidobacterium strains. Lett Appl Microbiol 67(5):497–505
Sindhu SS, Dadarwal KR (2001) Chitinolytic and cellulolytic Pseudomonas sp. antagonistic to fungal pathogens enhances nodulation by Mesorhizobium sp. cicer in chickpea. Microbiol Res 156(4):353–358
Singh A, Jain A, Sarma BK, Upadhyay RS, Singh HB (2014) Rhizosphere competent microbial consortium mediates rapid changesin phenolic profiles in chickpea during Sclerotium rolfsii infection. Microbiol Res 169:353–360
Skujin JJ, Potgieter HJ, Alexunder M (1965) Dissolution of fungal cell wall by Streptomyces Chitinase and β(1–3) glucanase. Arch Biochem Biophy 111:358–364
Smolińska U, Kowalska B (2018) Biological control of the soil-borne fungal pathogen Sclerotinia sclerotiorum––a review. J Pl Pathol 100(1):1–12
Solanki MK, Kumar S, Pandey AK, Srivastava S, Singh RK, Kashyap PL, Srivastava AK, Arora DK (2012) Diversity and antagonistic potential of Bacillus spp. associated to the rhizosphere of tomato for the management of Rhizoctonia solani. Biocontrol Sci Tech 22(2):203–217
Spilker T, Coenye T, Vandamme P, LiPuma JJ (2004) PCR-based assay for differentiation of Pseudomonas aeruginosa from other Pseudomonas species recovered from cystic fibrosis patients. J Clin Microbiol 42:2074–2079
Sutrisno A, Ueda M, Abe Y, Nakazawa M, Miyatake KA (2004) Chitinase with high activity toward partially N-acetylated chitosan from a new, moderately thermophilic, chitin-degrading bacterium, Ralstonia sp. A-471. Appl Microbiol Biotechnol 63:398–406
Trotel-Aziz P, Couder M, Biagianti S, Aziz A (2008) Characterisation of new bacterial biocontrol agents Acinetobacter, Bacillus, Pantoea and Pseudomonas sp. mediating grapevine resistance against Botrytis cinerea. Environ Exp Bot 64:21–32
Ueda M, Kotani Y, Sutrisno A, Nakazawa M, Miyatake K (2005) Purification and characterization of chitinase b from moderately thermophilic bacterium Ralstonia sp. A-471. Biosci Biotechnol Biochem 69(4):842–844
Upadyay SK, Maurya SK, Singh DP (2012) Salinity tolerance in free living plant growth promoting Rhizobacteria. Ind J Sci Res 3:73–78
Wang N, Liu M, Guo L, Yang X, Qiu D (2016) A novel protein elicitor (PeBA1) from Bacillus amyloliquefaciens NC6 induces systemic resistance in tobacco. Int J Biol Sci 12(6):757–767
Xian L, Wang F, Luo X, Feng YL, Feng JX (2015) Purification and characterization of a highly efficient calcium-independent α-amylase from Talaromyces pinophilus. PLoS ONE 10(3):1–95
Acknowledgements
The present investigation was conducted at Pulses section, Department of Plant Breeding and Genetics, Punjab Agricultural University. The authors are thankful to Department of Microbiology, Punjab Agricultural University, Ludhiana, Punjab, India for further support and Department of Science and Technology (DST), New Delhi, for funding as doctoral fellowship to the first as well as the corresponding author of the manuscript.
Funding
The authors are thankful to Punjab Agricultural University, Ludhiana, Punjab, India for providing facilities and Department of Science and Technology (DST), New Delhi, for funding as doctoral fellowship to the first as well as the corresponding author of the manuscript.
Author information
Authors and Affiliations
Contributions
First author: Dr. (Mrs.) SK (Corresponding Author). Specific contribution: Planning and execution of the represented research work, Writing and editing of the manuscript. Second author: Dr. (Mrs.) VK. Specific contribution: Planning of the experiments included in this study, reviewing the manuscript. Third author: Dr. AS. Specific contribution: Assistance in the experiments especially SDS-PAGE analysis included in this study.
Corresponding author
Ethics declarations
Conflict of interest
The authors declare that they have no conflict of interest. The first author Dr. Suman Kumari declares that she has no conflict of interest. The second author Dr. Veena Khanna declare that she has no conflict of interest and the third author Dr. Alla Singh also declare that he has no conflict of interest.
Ethics approval
This article does not contain any studies with human participants or animals performed by any of the authors.
Consent to participate
All the persons that have contributed to this manuscript are presented as authors in series according to his her/ contribution. There is no other person that has contributed and is not acknowledged. All the authors agree for their place in author list as presented/submitted.
Consent for publication
The corresponding author declare that no content/data or material has been presented in the manuscript other than the corresponding author’s of only this manuscript (with reference). All the authors declare the same.
Availability of data and material
The authors declare that the data supporting the findings of this study are available within the article itself.
Code availability
Not applicable.
Additional information
Publisher's Note
Springer Nature remains neutral with regard to jurisdictional claims in published maps and institutional affiliations.
Supplementary Information
Below is the link to the electronic supplementary material.
Rights and permissions
About this article
Cite this article
Kumari, S., Khanna, V. & Singh, A. Characterization and evaluation of extracellular hydrolytic proteins from rhizobacterial antagonists isolated from Fusarium oxysporum f. sp. ciceris infected chickpea fields. Indian Phytopathology 75, 165–177 (2022). https://doi.org/10.1007/s42360-021-00443-y
Received:
Revised:
Accepted:
Published:
Issue Date:
DOI: https://doi.org/10.1007/s42360-021-00443-y